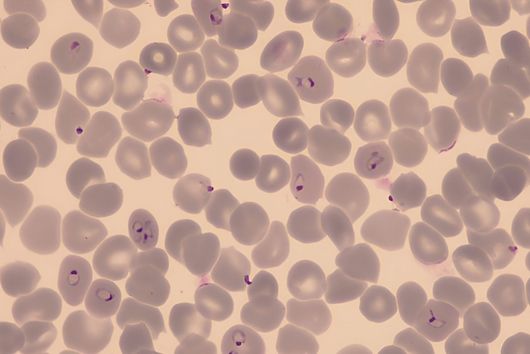
Red blood cells infected with Plasmodium falciparum

Pharmaceutical research for novel anti-infectives
The Helmholtz Institute for Pharmaceutical Research Saarland (HIPS) focuses on the development of novel anti-infectives by combining state-of-the-art medicinal chemistry and natural product based research with innovative drug delivery approaches.
Research at HIPS
Research at HIPS is based on the following four research areas: Microbial Natural Products, Drug Design and Optimization, Biological Barriers and Delivery, and Drug Bioinformatics. Close collaboration between these research areas allows us to streamline the development of novel anti-infectives.
News
Stay up to date with upcoming events and research activities at HIPS and read all about the latest results of our work.
"Development of novel antibiotics is currently only possible in close collaboration with various academic and industrial partners. We aim to bridge the translational gap caused by market failure in numerous collaborations and public private partnerships to enable anti-infective development in the fight against antimicrobial resistance."
Rolf Müller, Managing Director of the Helmholtz Institute for Pharmaceutical Research Saarland (HIPS) and Head of the Department Microbial Natural Products
Join HIPS
Become a part of HIPS and join the fight against antimicrobial resistance! Learn more about career opportunities at HIPS and find out about our current vacancies.